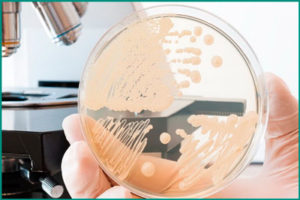
image

Содержание
Мочеполовая система организма является одной из наиболее чувствительных. Даже незначительное переохлаждение, неожиданный половой контакт и даже избыток жирной пищи могут привести к неприятным заболеваниям. Патологии, связанные с органами малого таза, значительно ухудшают качество жизни человека. Однако благодаря прогрессу в медицине, были разработаны антибактериальные препараты, которые помогают избавиться от многих недугов. Применение антибиотиков при уретрите является наиболее распространенным и эффективным способом восстановления здоровья.
Коротко об уретрите
Уретрит – это воспалительное заболевание мочеиспускательного канала, которое проявляется дискомфортными ощущениями при мочеиспускании и неприятным запахом выделений. Это заболевание встречается как у мужчин, так и у женщин, но из-за особенностей анатомии мужского полового органа оно может протекать более тяжело.
Причины уретрита могут быть различными. Одна из категорий – это инфекционные заболевания, вызванные различными возбудителями, такими как гонококки и другие бактерии. Также уретрит может быть результатом травмы, аллергической реакции, использования катетеров или сужения уретры.
Характерные симптомы уретрита включают болевые ощущения, жжение и резь при мочеиспускании, а также утренние выделения из уретры. Если не обратиться за медицинской помощью вовремя, воспаление может распространиться на мочевой пузырь и другие органы половой системы, что может привести к орхиту, простатиту, эпидидимиту и даже мужскому бесплодию.
Лечение уретрита антибактериальными средствами
Врач направляет пациента на специальное обследование, чтобы определить возбудителя заболевания и разработать соответствующую тактику лечения. Обычно это включает посев биологического материала, проведение ПЦР-анализа и определение титров антител. Эти процедуры являются стандартными и необходимыми.
Цели применения
Терапевтическая стратегия имеет две основные цели: устранение воспалительного очага и восстановление мочеиспускательного канала. Первая проблема успешно решается с помощью антибиотиков. Кроме основного курса, также используются процедуры прямого введения антисептиков в уретру.
Для борьбы с возбудителем заболевания используются различные лекарственные препараты, такие как макролиды, тетрациклины, фторхинолоны и пенициллины. В случае осложнений может потребоваться одновременное применение двух антибиотиков. Обычно лечение длится около десяти дней.
Несвоевременное прекращение лечения может привести к опасным изменениям в патологии и переходу в хроническую форму.
Механизм действия на примере наиболее применяемой группы препаратов
Тетрациклиновые препараты являются самыми популярными антибиотиками для лечения уретрита у мужчин и женщин. Эта группа лекарств имеет несколько преимуществ и оказывает следующее воздействие:
- прямолинейно и целенаправленно корректирует воспалительную область;
- предотвращает привыкание болезнетворных микроорганизмов;
- требует меньшего количества препарата;
- имеет более короткий срок лечения;
- минимизирует возникновение побочных эффектов.
Важно отметить, что эффективность выбранных препаратов определяется анализом, который проводится после завершения терапии. Идеально, результаты анализа должны показывать полное отсутствие вредоносных микробов. В противном случае, антибактериальное лечение продолжается с применением препаратов другой группы.
Выбор оптимальных средств борьбы с уретритом
Поиск подходящего антибактериального препарата является крайне важным. Каждый вид микроорганизма может быть чувствителен только к определенному препарату, в то время как другие виды могут быть чувствительны к нескольким. Поэтому необходимо провести своевременную и тщательную диагностику заболевания. Для определения наличия уретрита и типа возбудителя инфекции используются следующие методы:
- Лабораторные анализы мочи, включающие микроскопический и микробиологический анализы.
- Бакпосев выделений и мазков из мочевого канала, позволяющий определить чувствительность микробов к антибиотикам.
- Полимеразная цепная реакция (ПЦР).
Неправильный выбор антибиотика может только усугубить болезнь. Часто урологи назначают пациентам антибиотики широкого спектра действия. В таких случаях особенно важно соблюдать правильную дозировку и продолжительность лечения. Для лечения уретрита чаще всего назначаются следующие препараты:
- "Доксициклин" – популярный препарат из группы тетрациклинов, который быстро действует независимо от стадии заболевания и характеризуется высокой эффективностью.
- "Азитромицин" – препарат, который мгновенно останавливает рост бактерий и эффективен при хламидиозе.
- "Сумамед" – считается наиболее безопасным для организма человека, согласно многочисленным отзывам пациентов.
В большинстве случаев лечение уретрита проводится дома. Вместе с приемом синтетических лекарств рекомендуется употреблять большое количество жидкости, особенно полезным является клюквенный морс.
Антибиотики при разных видах заболевания
Лекарственные препараты для уретрита подбираются в зависимости от его разновидности. В таблице ниже представлены типы инфекции и соответствующие антибиотики, которые рекомендуется использовать.
| Тип заболевания | Рекомендуемые препараты |
|---|---|
| Неспецифический | Любой антибиотик широкого спектра действия, такой как "Сульфазол", "Цефтриаксон" или "Метронидазол". |
| Гонорейный | Необходимы препараты, способные уничтожать хламидии, например, "Спектиномицин". |
| Вирусный | Требуются специфические иммуноукрепляющие таблетки. |
| Трихомонадный | Лечение проводится с помощью противомикробных свечей, например, "Йодовидон". |
Препараты для лечения уретрита с циститом
Патологии мочеполовой системы часто проявляются в комплексе. Уретрит и цистит – это воспалительно-инфекционные заболевания органов малого таза. Оба заболевания имеют схожие симптомы, но отличаются местоположением и показателями анализов.
Лечение этих нарушений осуществляется с использованием аналогичных препаратов.
Для нормализации состояния мочеполовой системы часто используются антибиотики четвертого поколения от уретрита. Они отличаются мягким воздействием на источник патологии. Вот список самых популярных препаратов:
- "Монурал". Эффективен против бактериального цистита и хламидийного уретрита. Нейтрализует стафилококк. Почти не имеет побочных эффектов.
- "Цефорал". Быстро воздействует на патогенные организмы. Не рекомендуется применять во время беременности.
- "Нолицин". Этот препарат необходим при острых и хронических инфекциях мочевых органов. Уничтожает патогенную флору и хорошо справляется с воспалением.
При применении антибактериальных препаратов также необходимо принимать средства для нормализации микрофлоры организма.
Медикаментозная терапия при неспецифическом типе воспаления
Антибиотикотерапия успешно лечит неспецифическое воспаление, если известна точная причина инфекции. Обычно грибы Candida, вирусы герпеса и бактерии Klebsiella, Proteus и Staphylococcus aureus являются провокаторами этого заболевания. Наличие этих микроорганизмов, вместе с факторами, такими как недостаточная физическая активность, ослабление иммунитета, вредные привычки, способствуют развитию и прогрессированию этого недуга.
Сульфаниламидные препараты эффективно воздействуют на жизнеспособность патогенов. Соблюдение правил гигиены, увеличение потребления жидкости и ограничение физической активности усиливают положительное влияние лекарственной терапии. Совместный прием лекарств с половым партнером необязателен, если врач не обнаружил вторичную инфекцию.
Уретрит смешанной этиологии
Смешанный уретрит может возникнуть из-за инфицирования гонококками или комбинации различных микроорганизмов. Неправильное хирургическое вмешательство, венерические заболевания и медицинские процедуры могут стать частыми причинами попадания патогенных микробов в мочеполовую систему.
Для лечения смешанного уретрита применяется комплексная терапия, включающая широкий спектр антибиотиков и, при необходимости, антивирусные препараты. Если после прохождения лекарственного курса требуется коррекция, физиотерапия, растительные и гомеопатические препараты активно используются.
Уретрит после антибиотиков
Уретрит может повторно возникнуть после применения антибиотиков. Это связано с наличием условно-патогенной микрофлоры в промежности, на головке пениса и в женском влагалище. Некорректное начальное лечение является второй причиной рецидивов, так как бактерии не полностью исчезают, патология не проходит и переходит в хроническую стадию. В таких случаях лечение включает применение противогрибковых средств, таких как "Нистатин" и "Флуконазол", а антибиотики не используются.
Лекарства, подходящие мужчинам
У мужчин мочеполовые заболевания имеют свои особенности, связанные с различиями в строении соответствующих органов. Например, у мальчиков уретра имеет S-образную форму, длиннее и содержит пять анатомических сужений. В связи с этим, мужчины чаще подвержены заболеванию мочеиспускательного канала и страдают от него более тяжело.
Лечение хронического уретрита у мужчин требует длительного курса. Для снятия болевых ощущений широко применяются различные спазмолитики, такие как "Но-шпа", "Папаверин", "Бенциклан" и "Бендазол". Вместе с этим, специалисты рекомендуют принимать противовоспалительные препараты, такие как "Ибупрофен", "Нимесил" и "Диклофенак".
Для лечения уретрита у мужчин часто используются антибиотики, такие как "Доксициклин", "Гентамицин", "Сумамед" и "Ацикловир". Для наружного применения подходят растворы марганцовки и настои цветков ромашки аптечной.
Лучшие препараты для женщин
Противомикробные препараты играют важную роль в лечении воспалительных процессов у обоих полов. Однако, существует особая группа антибиотиков, которые применяются преимущественно при уретрите у женщин:
- «Нитроксолин» – назначается для лечения острых, хронических и рецидивирующих инфекций мочевыводящих путей.
- «Фурадонин» – следует использовать с осторожностью, так как может вызывать множество побочных эффектов.
- «Бисептол» – это комбинированный противомикробный препарат с широким спектром действия.
- «Фурагин» – является производным нитрофурана и специализируется на лечении только мочеполовых инфекций. Он противопоказан при заболеваниях почек и печени.
- «Трихопол» – основное действующее вещество в нем – метронидазол.
Важно помнить! Во время приема этих таблеток необходимо следить за появлением подозрительных симптомов. Частыми побочными признаками являются тошнота, сонливость и ухудшение зрения. Если эти неприятные проявления вызывают дискомфорт, обязательно сообщите об этом вашему врачу. Возможно, вам придется сменить препарат.
Примерный перечень антибактериальных средств для лечения уретрита
В таблице ниже представлены списки наиболее распространенных лекарств, разделенные на мужские и женские препараты, которые чаще всего используются в медицинской практике:
| Мужские медикаменты | Женские препараты |
|---|---|
| Антибиотик "Доксициклин" для лечения хламидийного уретрита | "Цефалоспорин" |
| "Азитромицин", также известный как "Сумамед" | "Спектиномицин" |
| "Гентамицин" | "Цефаклор" |
| "Кларитромицин" | "Метронидазол" |
| "Офлоксацин" | "Бензидамин" |
| "Эритромицин" и "Йодовидон" в свечах | "Йодовидон" в свечах |
| "Левофлоксацин" | "Леворин" |
| "Доксициклин" | "Нистатин" |
| "Ацикловир" | "Тетрациклин" в таблетках |
| "Рибоверин" | "Бисептол" |
| "Фамцикловир" | "Нитроксолин" |
| "Герпевир" | "Трихопол" |
Восстановление организма после курса антибиотикотерапии
Прием антибиотиков всегда может привести к нарушению кишечной микрофлоры, которая играет важную роль в иммунитете человека. Поэтому восстановление защитных сил организма зависит от реабилитации слизистых оболочек желудочно-кишечного тракта. Пробиотики, такие как фруктоолигосахариды (ФОС), галактоолигосахариды (ГОС) и лактулоза, могут быстро нормализовать внутренние процессы. Если после приема антибиотиков возникает кандидоз, можно применить противогрибковые средства, например, "Флуконазол".
Восстановление здоровья после курса антибактериальных препаратов можно достичь с помощью правильного питания и народных средств. Существуют эффективные методы, которые способствуют быстрой реабилитации всех биосистем:
- Употребление большого количества жидкости (до 2 литров в день).
- Кисломолочные продукты, такие как йогурты и кефиры, необходимы для нормализации микрофлоры кишечника.
- По рекомендации аюрведы, можно приготовить напиток из чайного гриба, который содержит множество полезных микроэлементов.
- Квашеная капуста является источником витаминов, которые укрепляют иммунитет.
- Сок свеклы повышает уровень эритроцитов в крови и может быть принят внутрь, разведенный кипяченой водой.
Длительность восстановительного периода может варьироваться в зависимости от вида принимаемых антибиотиков и продолжительности лечения.
Заключение
Антибиотики являются настоящим спасением для человечества, так как они позволяют излечить множество ранее неизлечимых заболеваний. Однако, важно помнить, что неправильное использование этих лекарств может причинить больше вреда, чем пользы. Поэтому самолечение бактериальных инфекций не рекомендуется. Вместо этого, рекомендуется принимать пробиотики, следовать правильному режиму питья и питания, чтобы снизить возможные негативные последствия медикаментозной терапии при заболеваниях мочеполовой системы. Профилактические меры против таких патологий довольно просты и очевидны: избегать переохлаждения, соблюдать правила личной гигиены и укреплять иммунитет.